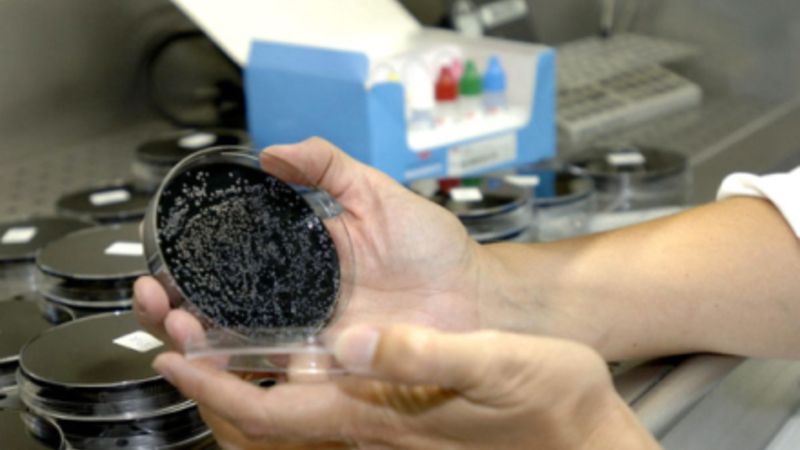

Nyt dødsoffer og flere smittede
Skrevet af Torben Wilkenschildt, man, 16/07/2012 - 12:01
Sundhed & sygdom
Den frygtede legionella-syge har i weekenden krævet endnu et dødsfald. En 63-årig kvinde, som var indlagt på sygehus i Villajoyosa i Alicant...
Den frygtede legionella-syge har i weekenden krævet endnu et dødsfald. En 63-årig kvinde, som var indlagt på sygehus i Villajoyosa i Alicante, er død, efter at hun blev smittet med den dødsensfarlige legionella-virus.
Det første offer, en 87-årig kvinde, døde den 7. juli på sygehus i Alcorcón.
Ud over de to dødsfald er 63 personer smittet, efter at de havde spist på en fiske-restaurant i Madrid. Det første tilfælde blev opdaget den 12. juni.

Man mistænker hotellets spa for at være smittekilden
Ud over sagen fra Madrid er 17 personer smittet med legionella efter et ferieophold på et hotel i Calpe på Costa Blanca. Ifølge sundhedsmyndighederne er der fundet to nye tilfælde af legionella-smitte fra et udbrud på Diamond Beach hotel i Calpe.
Hotellet har været lukket siden udbruddet startede. Meget tyder på, at smitten stammer fra hotelles spa, og hotellet kan nu ventes genåbnet når som helst, siger formanden for sundhedsudvalget i Valencia, Luis Rosado.
Hotellets spa vil dog være lukket ind til videre.
Kan måske også interessere dig
Spanien fastholder den globale førertrøje inden for transplantationer
Tallene for 2025 understreger den imponerende indsats, men hvordan ser det ud i Danmark?
El Gordo 2025: Millionerne rullede ud over Madrid og León
Traditionen tro har hele Spanien i dag holdt vejret, mens børnene fra San Ildefonso-skolen sang de magiske numre .
Cataloniens smaragdgrønne naturlige svømmepøl
Smuk middelalderbro med turkis vand kun halvanden time fra Barcelona.
Kommentarer
Der er endnu ingen kommentarer til denne artikel
COPYRIGHT: Det er ikke tilladt at kopiere hverken helt eller delvist fra Spanien i dag uden aftale.
Gratis i din indbakke hver dag!
Abonnér på nyhedsbrevet Spanien i Dag og vær på forkant med begivenhederne.
Klik her for at tilmelde dig.




















